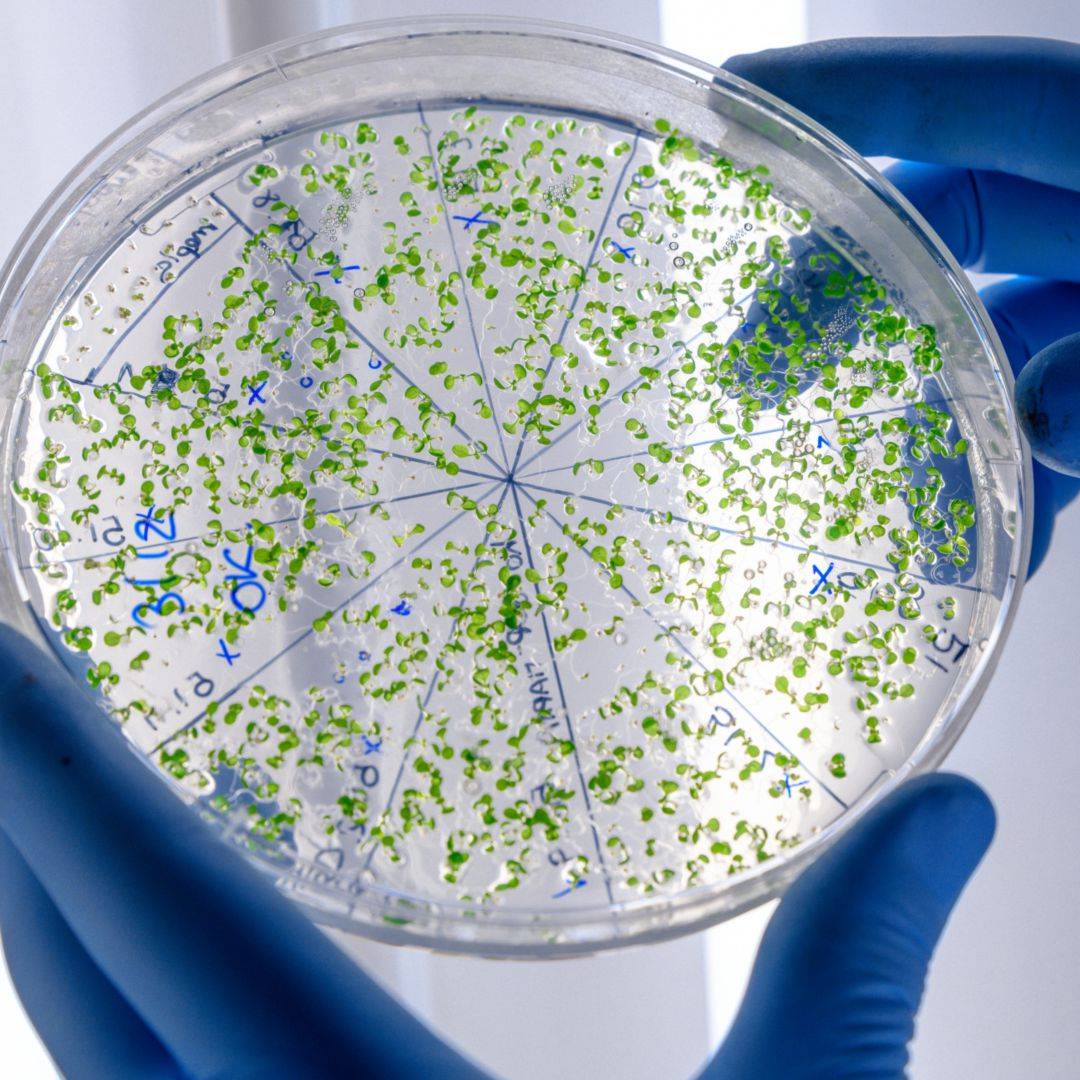

GEIMSA STAIN
Advanced Staining Technique for Detailed Skin Analysis
Call NowAt Signature Skin, our Geimsa Stain Services offer an advanced staining technique used in dermatology for detailed analysis of skin cells and structures. Dr. Shantanu Choudhary and Dr. Swati Mogra, alongside our specialized dermatologists, employ Geimsa staining to enhance the visualization and identification of specific cells and microorganisms in skin samples.
Understanding Geimsa Stain
Geimsa stain is a specialized staining method that involves the use of Geimsa dye to stain skin samples for microscopic examination. This technique allows for enhanced visualization of cellular structures, making it valuable in diagnosing various skin conditions.
Applications of Geimsa Stain

Microscopic Analysis
Geimsa staining aids in the microscopic analysis of skin cells, facilitating the identification of cellular abnormalities or microorganisms.
Identification of Pathogens
It assists in identifying and studying certain microorganisms, such as bacteria, fungi, or parasites present in skin samples.

Cellular Abnormalities
Geimsa staining helps in detecting cellular abnormalities associated with certain skin diseases or infections.
Why Choose Signature Skin for Geimsa Stain?
When you choose Signature Skin for Geimsa Stain Services, you benefit from:
Specialized Dermatologists: Our team consists of experts skilled in Geimsa staining techniques for accurate skin sample analysis.
Advanced Staining Methods: We utilize Geimsa staining to enhance the visualization of skin cells and microorganisms for precise analysis.
Diagnostic Precision: Geimsa staining enables detailed examination, aiding in the accurate diagnosis of various skin conditions.
Comprehensive Analysis: We conduct thorough microscopic analyses using Geimsa stain to ensure a comprehensive evaluation of skin samples.
Detailed Skin Analysis for Informed Diagnoses
Geimsa staining is a valuable technique in enhancing the visualization and analysis of skin samples, aiding in precise diagnoses. At Signature Skin, our goal is to provide comprehensive Geimsa Stain Services for accurate skin sample analysis and detailed diagnostic insights.
If you require detailed skin analysis or have concerns requiring microscopic examination, schedule a consultation with our specialists. Contact Signature Skin now for advanced Geimsa staining services and precise skin sample analysis.